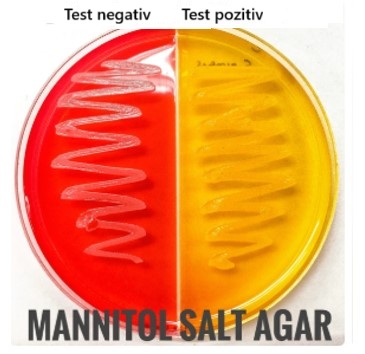

MSADr. Stănescu explică faptul că în acest caz este necesar un mediu neselectiv. MSA este selectiv pentru bacteriile Gram-pozitive, în special stafilococi, datorită concentrației sale mari de sare, care inhibă majoritatea celorlalte bacterii. De asemenea, se diferențiază pe baza fermentării manitolului.
Website: https://www.shutterstock.com/image-photo/s-sepidermidis-on-mannitol-salt-agar-1522128641
Deși este valoros pentru identificarea Staphylococcus aureus în anumite contexte, nu este ideal pentru detectarea contaminării bacteriene generale, deoarece exclude multe tipuri de bacterii care ar putea fi prezente într-o probă diversă. Să încercăm din nou! |
Map: CS11 - CULTURA ȘI CREȘTEREA MICROBIANĂ - ROMANIAN (1053)
|
||
|
Review your pathway |